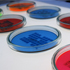

the land seen from the sea
exhibition
february 4 - may 4, 2012
museum for contemporary art, villa croce
genoa, italy
Yuula Benivolski (CA); Justine Blau (L);
Canarezza & Coro (RSM); Martina Conti (RSM)(F);
Nina Danino (GB); Oppy De Bernardo (CH);
Hekla Dogg Jonsdottir (IS); Doris Drescher (L);
Haris Epaminonda (CY); Barbara Geyer (FL);
Anna Hilti (FL); Irena Lagator (MN);
Jose Ramón Lozano (E); Ingibjörg Magnadóttir (IS);
Mark Mangion (M); Mussoni & Albani (F)(RSM);
Giancarlo Norese e Umberto Cavenago (I);
Christodoulos Panayiotou (CY);
Paradise Consumer Group (AND);
Marco Poloni (CH); Pierre Portelli (M);
Luigi Presicce (I); Agnès Roux (MC);
Sigurður Atli Sigurðsson (IS); Miki Tallone (CH);
Xenia Uranova (RUS); Martin Walch (FL); Trixi Weis (L).
Curated by Alessandro Castiglioni, Rita Canarezza, Pier Paolo Coro, Roberto Daolio, Francesca Serrati
in collaboration with: Kevin Muhlen, Halldór Björn Runólfsson
Swetlana Racanović
see press release e-flux
Little Constellation is a project and an international network for contemporary art, which focuses its research on the symbolic sensitivity of the geographic dimension. Highlighting the different possible relationship between the geo-cultural centres and peripheries, through a plan of knowledge taken to the extreme of opposition and resistance between the concepts of proximity and distance, from January 2012, at the Museo di Villa Croce in Genoa, it will present the exhibition The Land Seen from the Sea.
Little Constellation conducts research devoted to the complex theme of isolation, which finds its definition in the dimension of the island (both geographically, but naturally also linguistically).
Isolation and the network of relationships are thus intertwined as fields of a single front. We live around a sea like frogs around a pond, declared Socrates. This brings out the fact that the peoples of antiquity owed their prosperity and relations to the great sea (almost enclosed like a pond) that is the Mediterranean. It is this duality between distance and vicinity that the research project seeks to focus on.
This research therefore focuses on the Mediterranean by starting from particularly sensitive areas, such as Montenegro, Malta, San Marino, Cyprus, Gibraltar, Ceuta, and also other areas with which it is possible to make cultural and geographical comparisons, such as Iceland, Luxembourg, Andorra and Liechtenstein.
Specifically, the multiple identities of the Mediterranean will be examined through three nuclear and seminal case studies, compared with the different cultures encountered in this small basin.
These three areas are:
- Cyprus and its relations with Oriental cultures (Turkish, Arabic and Indian)
- Malta as a bridge between the North African basin and continental Europe
- Gibraltar (and Ceuta), and relations with the Atlantic and English-speaking cultures
Viewed in this perspective, these three different areas become useful mediums for broader anthropological, cultural and social reflection on the Mediterranean, which Fernand Braudel described as “a constant encounter between past and present. History is no more than a continuous series of questions aimed at the past in the name of the problems and curiosity – as well as the concerns and anxieties – of the present that surrounds and besets us. More than any other human universe the Mediterranean is proof of this, endlessly narrating itself and living on. Having been is a condition for being.”
The preparatory phase of this complex project will be developed in a specific dialogical dimension in collaboration with different institutions and artists which have been collaborating with the network for some years now.
Specifically, between October 2011 and January 2012 Rita Canarezza, Pier Paolo Coro and Alessandro Castiglioni will conduct a series of workshops, laboratories and round tables with the aim of developing open discussion around the themes of the exhibition, which in their broadest terms are issues of an anthropological and geopolitical nature which characterize the territories in question. From isolation to distance, from autoproduction to the relations between artistic research and the territorial specifics, these workshops will be held in major venues for contemporary art research and will see the participation of scholars, theorists and artists.
Republic of San Marino; Their Excellencies the Captains Regent; Secretariat of State for Foreign and Political Affairs; Secretariat of State for Education and Culture, University and Youth Policies; Secretariat of State for Tourism and Sport; Office for Social and Cultural Activities.
City of Genoa, Department of Culture, Villa Croce Museum of Contemporary Art
project partners: MUDAM, Musée d’Art Moderne Grand - Duc Jean, Luxembourg; Casino Luxembourg - Forum d’art contemporain, Luxembourg; National Gallery of Iceland, Iceland; CIA.IS Center for Icelandic Arts; Brown Project Space, Milan; Malta Contemporary Art, Malta; Cultural Services Cyprus; The Nicosia Municipal Arts Centre, Cyprus; La Rada, Locarno, Canton Ticino / CH.
Museo d’Arte Contemporanea Villa Croce - Genova
Via Jacopo Ruffini 3 (16128), Italy -
+39 010580069 - +39 010532482 (fax)
www.museidigenova.it
www.littleconstellation.org
exhibition
february 4 - may 4, 2012
museum for contemporary art, villa croce
genoa, italy
Yuula Benivolski (CA); Justine Blau (L);
Canarezza & Coro (RSM); Martina Conti (RSM)(F);
Nina Danino (GB); Oppy De Bernardo (CH);
Hekla Dogg Jonsdottir (IS); Doris Drescher (L);
Haris Epaminonda (CY); Barbara Geyer (FL);
Anna Hilti (FL); Irena Lagator (MN);
Jose Ramón Lozano (E); Ingibjörg Magnadóttir (IS);
Mark Mangion (M); Mussoni & Albani (F)(RSM);
Giancarlo Norese e Umberto Cavenago (I);
Christodoulos Panayiotou (CY);
Paradise Consumer Group (AND);
Marco Poloni (CH); Pierre Portelli (M);
Luigi Presicce (I); Agnès Roux (MC);
Sigurður Atli Sigurðsson (IS); Miki Tallone (CH);
Xenia Uranova (RUS); Martin Walch (FL); Trixi Weis (L).
Curated by Alessandro Castiglioni, Rita Canarezza, Pier Paolo Coro, Roberto Daolio, Francesca Serrati
in collaboration with: Kevin Muhlen, Halldór Björn Runólfsson
Swetlana Racanović
see press release e-flux
Little Constellation is a project and an international network for contemporary art, which focuses its research on the symbolic sensitivity of the geographic dimension. Highlighting the different possible relationship between the geo-cultural centres and peripheries, through a plan of knowledge taken to the extreme of opposition and resistance between the concepts of proximity and distance, from January 2012, at the Museo di Villa Croce in Genoa, it will present the exhibition The Land Seen from the Sea.
Little Constellation conducts research devoted to the complex theme of isolation, which finds its definition in the dimension of the island (both geographically, but naturally also linguistically).
Isolation and the network of relationships are thus intertwined as fields of a single front. We live around a sea like frogs around a pond, declared Socrates. This brings out the fact that the peoples of antiquity owed their prosperity and relations to the great sea (almost enclosed like a pond) that is the Mediterranean. It is this duality between distance and vicinity that the research project seeks to focus on.
This research therefore focuses on the Mediterranean by starting from particularly sensitive areas, such as Montenegro, Malta, San Marino, Cyprus, Gibraltar, Ceuta, and also other areas with which it is possible to make cultural and geographical comparisons, such as Iceland, Luxembourg, Andorra and Liechtenstein.
Specifically, the multiple identities of the Mediterranean will be examined through three nuclear and seminal case studies, compared with the different cultures encountered in this small basin.
These three areas are:
- Cyprus and its relations with Oriental cultures (Turkish, Arabic and Indian)
- Malta as a bridge between the North African basin and continental Europe
- Gibraltar (and Ceuta), and relations with the Atlantic and English-speaking cultures
Viewed in this perspective, these three different areas become useful mediums for broader anthropological, cultural and social reflection on the Mediterranean, which Fernand Braudel described as “a constant encounter between past and present. History is no more than a continuous series of questions aimed at the past in the name of the problems and curiosity – as well as the concerns and anxieties – of the present that surrounds and besets us. More than any other human universe the Mediterranean is proof of this, endlessly narrating itself and living on. Having been is a condition for being.”
The preparatory phase of this complex project will be developed in a specific dialogical dimension in collaboration with different institutions and artists which have been collaborating with the network for some years now.
Specifically, between October 2011 and January 2012 Rita Canarezza, Pier Paolo Coro and Alessandro Castiglioni will conduct a series of workshops, laboratories and round tables with the aim of developing open discussion around the themes of the exhibition, which in their broadest terms are issues of an anthropological and geopolitical nature which characterize the territories in question. From isolation to distance, from autoproduction to the relations between artistic research and the territorial specifics, these workshops will be held in major venues for contemporary art research and will see the participation of scholars, theorists and artists.
Republic of San Marino; Their Excellencies the Captains Regent; Secretariat of State for Foreign and Political Affairs; Secretariat of State for Education and Culture, University and Youth Policies; Secretariat of State for Tourism and Sport; Office for Social and Cultural Activities.
City of Genoa, Department of Culture, Villa Croce Museum of Contemporary Art
project partners: MUDAM, Musée d’Art Moderne Grand - Duc Jean, Luxembourg; Casino Luxembourg - Forum d’art contemporain, Luxembourg; National Gallery of Iceland, Iceland; CIA.IS Center for Icelandic Arts; Brown Project Space, Milan; Malta Contemporary Art, Malta; Cultural Services Cyprus; The Nicosia Municipal Arts Centre, Cyprus; La Rada, Locarno, Canton Ticino / CH.
Museo d’Arte Contemporanea Villa Croce - Genova
Via Jacopo Ruffini 3 (16128), Italy -
+39 010580069 - +39 010532482 (fax)
www.museidigenova.it
www.littleconstellation.org